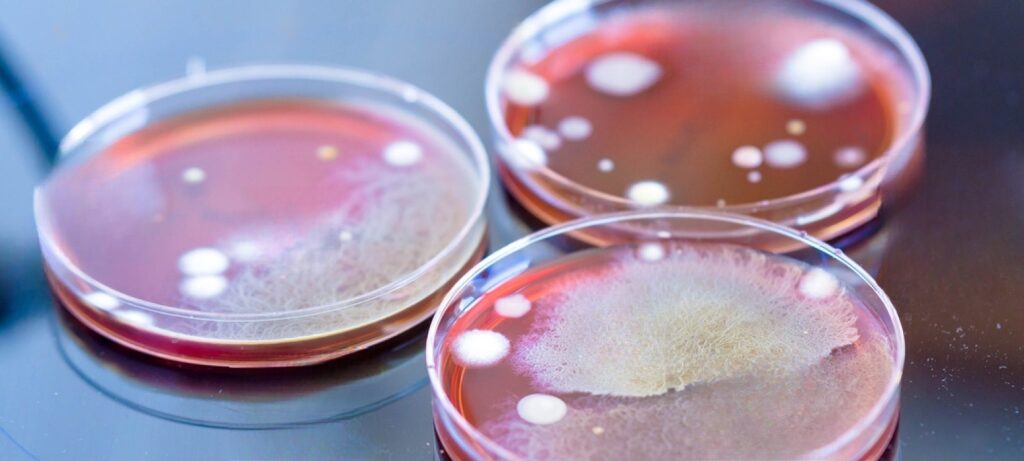

In the competitive landscape of the food, beverage, and pharmaceutical sectors, maintaining impeccable product quality is paramount. But beyond the eye-catching packaging and marketing campaigns lies a critical, yet often overlooked, aspect of the production process: CIP (Clean-In-Place) Validation.

Why is CIP Validation So Crucial?
CIP Validation isn’t just another box to tick on a compliance checklist—it’s a critical procedure that ensures the effectiveness of your cleaning processes. Ensuring your equipment is thoroughly cleaned is vital, not just for product quality but more importantly for consumer safety. Residues, contaminants, or even traces of cleaning agents can not only affect the taste, aroma, or efficacy of a product but can also pose health risks.
When CIP processes fall short, it’s not just the quality and integrity of the product at stake. There’s a more sinister issue lurking in the shadows: the potential health risks to consumers.
Bacterial Growth and Contamination: One of the most significant dangers of inadequate cleaning is the proliferation of harmful bacteria. Equipment nooks, crevices, and other hard-to-reach areas can harbor bacterial colonies if not cleaned effectively. Over time, these colonies can grow and contaminate products. Consumption of products tainted with harmful bacteria like E. coli, Listeria, or Salmonella can lead to severe illnesses, hospitalizations, or even death, especially in vulnerable populations such as the elderly, infants, or those with compromised immune systems.
Chemical Residues: Traces of cleaning agents left behind can pose their own set of health risks. Ingesting residues of caustic or acidic cleaning agents, even in small amounts, can irritate the gastrointestinal tract, leading to symptoms like nausea, vomiting, or diarrhea. Over time, consistent exposure to these residues may even lead to more serious health complications.
Allergenic Cross-Contamination: In facilities that process multiple products, inadequate cleaning can lead to cross-contamination between batches. For individuals with food allergies, even trace amounts of an allergen (like peanuts or gluten) can trigger severe allergic reactions, including anaphylaxis, which can be life-threatening.
Altered Product Efficacy: Particularly in the pharmaceutical sector, residues can interact with products, potentially reducing their efficacy or leading to unintended side effects. This poses a risk to patients relying on these medications for treatment.
Toxic Compounds Formation: In some scenarios, residues from one product can chemically interact with ingredients from another product, leading to the formation of toxic compounds. These compounds, when ingested, can have harmful or unpredictable effects on health.
Effective CIP Validation doesn’t just ensure a product meets taste or aesthetic standards. It’s a critical safeguard against a myriad of potential health risks. It’s a testament to the commitment of a business to prioritize the safety and well-being of its consumers above all else.
When Should You Perform CIP Validation?
Initial Implementation: Just installed a new piece of equipment or an entire CIP system? Now’s the time to validate.
Post-Modifications: Changed a procedure or tweaked a cleaning agent concentration? Re-validate.
Regular Intervals: Even if everything seems fine, periodic checks ensure that your CIP system remains consistently effective over time.
Data Logging and Issue Identification:
Data and measurements obtained during the CIP validation process can be a goldmine of information. These records aren’t just proof of compliance; they’re also a diagnostic tool. By meticulously logging data:
Spot Patterns: Notice a specific section consistently not meeting cleanliness standards? Maybe it’s a design flaw or a faulty spray nozzle.
Optimize Processes: Are certain cycles using more cleaning agents than needed, or could a process be made shorter without compromising on cleanliness?
Early Issue Detection: Before a minor residue issue becomes a full-blown batch contamination, the logged data can help in proactive troubleshooting.
The Oversight Dilemma:
So with all these benefits and the undeniable importance, why do many businesses skimp on CIP Validation?
Complacency: A mindset of “it’s always worked, so why change?”
Resource Constraints: Validation, especially the first few times, can seem resource-intensive.
Lack of Awareness: Especially in smaller enterprises (even though we also see it many big production facilities), there might be a genuine unawareness of the significance of validation.
However, the risks of overlooking CIP validation far outweigh the initial time and resources invested. A single compromised batch can lead to costly recalls, damage to brand reputation, and potential legal consequences.
How is CIP Validation Conducted?
CIP Validation isn’t a one-size-fits-all process, but it generally involves a structured and meticulous approach:
Visual Inspections: Initial checks involve visually assessing equipment after the cleaning process. This identifies gross contaminations and ensures surfaces appear clean.
Swab and Rinse Sampling: Specific areas, especially those hard to clean or high-risk zones, are swabbed or rinsed. These samples are then analyzed in a lab for chemical residues, allergens, or microbial contaminants.
Monitoring of Process Parameters: It’s vital to ensure that the cleaning process itself is consistent. This involves logging data on factors like temperature, cleaning agent concentration, flow rate, and duration.
Chemical and Microbiological Analysis: Advanced tools and techniques analyze the collected samples for residues, ensuring they are below accepted limits. Microbiological tests help detect bacterial or microbial growth.
Use of Tracers: Compounds like riboflavin can be used as tracers to visually verify that cleaning solutions reach all parts of the equipment, ensuring no spots are missed.
Logging and Analyzing Results: Every data point, observation, and result from the above steps is diligently logged. This logged information not only serves as a record for regulatory compliance but is an invaluable resource for continuous improvement. By analyzing these logs, businesses can identify trends, potential problem areas, and optimization opportunities, ensuring the CIP system remains at its peak efficiency and effectiveness.
Through this structured validation and diligent logging, businesses are not just ticking off a compliance requirement; they’re actively investing in the quality, safety, and continuous betterment of their products.
How can RESAB help you?
Every facility is unique, and so are its cleaning needs. With a record of designing hygienic facilities and conducting thorough CIP validations, we understand the nuances and complexities involved.
Experience Matters: We’ve been in the trenches, and we’ve successfully executed CIP validation multiple times. We don’t just offer solutions; we deliver results based on proven expertise.
Tailored to Your Needs: Every business is different. Our experts collaborate closely with you, devising a CIP validation system custom-fit to your facility’s specific demands.
Ease Your Load: Resources are valuable. Let us unload the burden from your shoulders, allowing your team to focus on what they do best, while we ensure your equipment meets the highest standards of cleanliness and safety.
Addressing Overlooked Aspects: We recognize that many businesses hesitate to implement CIP validation due to resource constraints, unawareness, or complacency. But we offer solutions to these challenges, ensuring that validation becomes an integrated, hassle-free part of your operations.
Take the Next Step Forward
Don’t let oversight compromise your product quality or the health of your consumers. Join hands with us, and together, let’s ensure the impeccable cleanliness of your facility. Reach out today and let us elevate your CIP processes.
